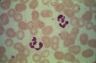

xii-01.jpg |
 xii-02.jpg |
 xii-03.jpg |
 xii-04.jpg |
 xii-05.jpg |
 xii-06.jpg |
 xii-07.jpg |
 xii-08.jpg |
 xii-09.jpg |
 xii-10.jpg |
 xii-11.jpg |
 xii-01.jpg |
xii-02.jpg |
 xii-03.jpg |
 xii-04.jpg |
 xii-05.jpg |
 xii-06.jpg |
 xii-07.jpg |
 xii-08.jpg |
 xii-09.jpg |
 xii-10.jpg |
 xii-11.jpg |